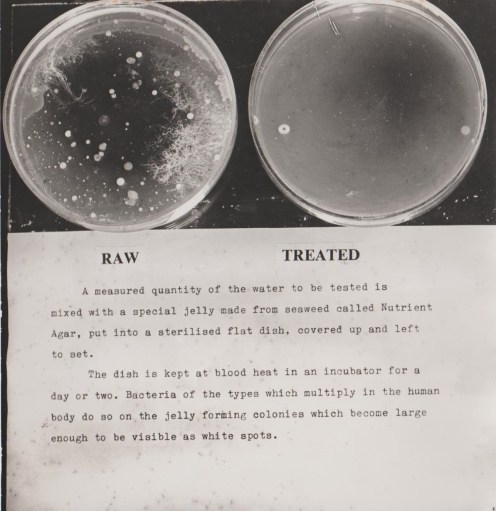
Agar Plates 001

For any comments or queries regarding this page
please contact David N Williams on pondside@talktalk.net
River supplies
Prior to the late 1700’s water was consumed directly, with no treatment, there were also no sewage systems. Often public sewage was tipped into the nearest stream or in towns a channel leading to a stream or river such as in Chelmsford High Street. As streams and rivers became more polluted, a growing number of people died from Typhoid and Cholera. Sand Filtration was introduced in the 1800’s, followed by universal chlorination in 1937.
Early simple method for counting Bacterial numbers
With early water sources such as rivers streams and some shallow wells becoming increasingly polluted by sewage, many people in towns such as London drank beer as a safer alternative. Deaths from enteric diseases such as Cholera and Typhoid grew with the population, killing thousands of the population

Death Rate from 1870 to 1945

Isabella Hazard, the first reported death from Cholera in Sunderland in 1831
In 1903 the County of Essex was regarded as remarkably healthy with a death rate of only 11.6 per 1000 population, whilst that of England and Wales was 16.3 and 15.4 respectively.
Wells and Boreholes
With shallow wells becoming easily polluted, the introduction of Deep wells and boreholes into the chalk provided a bacteriologically safe water supply. providing there was no ingress of surface water. The chemical constituency could vary enormously depending upon the strata the water passed through.

Filtration
Individual ceramic pot filters came into use in in the early 1800’s initially packed with powdered carbon until 1835, when Queen Victoria requested a filter for the royal household. Then a ceramic filter, was included which retained all bacteria etc larger than the pores in the ceramic. Viruses were not retained due to their small size.
Following this it was discovered that slow filtration through a bed of fine sand had the effect of rendering river water safe to drink. This method became the earliest form of water purification, for large public supplies. Slow sand filtration is very effective at removing water borne organisms, via a biological layer on the sand surface called a schmutzdecker. The Chelsea Water Co was formed in 1723, and installed the first sand filter in 1829 to filter water from the river Thames. By 1845 only 6 of the largest 50 towns in England had a safe water supply.
One drawback with the Slow sand filters is that they are prone to blocking by large algal blooms, reducing substantially the output of the treatment plant, whereas the algae penetrate the rapid filters, giving discoloured water in supply.


The majority of treatment works abstracting river water currently use dual sand filtration, first small rapid gravity filters to remove suspended matter followed by slow sand for purification. A low residual chlorine dose was applied prior to the water entering the distribution system

Chlorination
Chlorination became the universal purification agent, first being used in 1897 as a powder, but not made compulsory until after the outbreak of Typhoid in Croydon in 1937. It is normally dosed as a gas through an injector
Softening
Those supplies that were required to be softened, often used lime, this process (The Clark’s Process) was developed by Dr Clark of Edinburgh in 1841, This removed the temporary hardness, Ca (OH)2, ie that could be removed by boiling. However if low hardness levels were required Soda Ash (Na2 CO3 ) was also required to remove the permanent hardness ie Calcium Sulphate. Where an excess of lime was used it was found to have a purification effect reducing bacterial contamination. Mr P Frankland reported in 1985 of the bacterial reduction in both well water and that of the River Thames when using the Clark’s process. Reported in 1914 the water supply to Cincinnati, used this process and trials were also conducted on River Thames water in 1912. This method was permitted in a Parliamentary Bill for the city of Aberdeen in 1914 , which was a soft water. A later bill for the Chelmsford Corporation in 1922 allowed this for a hard river water. However this did not come on stream until 1930 which was after the Southend Waterworks Company in 1927.

In 1885 it was noted that water softened with lime also provided a significant reduction in Bacteria if the lime concentration was in excess of that required to remove the temporary hardness, and in Cincinatti, Ohio this Excess Lime Method was utilised successfully in 1889. In 1912 this was successfully trialled on the River Thames and used for public supply in Aberdeen in 1915. Softening works usually have rapid gravity sand filters followed by a small residual chlorine dose.
Quality Complaints
Water quality complaints fall into three main categories, Taste and Odour, Discoloured Water, and Animals.
Taste and Odour
These fall into two main categories, those originating from earthy algal, and musty tastes and those such as chlorinous tastes derived from chemical addition.
River and Reservoir waters are often associated with algal blooms and decay, which impart specific tastes and odours. Initially powdered activated carbon was used to absorb these. Later methods involved dosing with ozone followed by absorbtion in activated carbon filter beds.
Chlorination, the chlorine content steadily decreases as the water travels through the distribution system, with the greater loss taking place in the smaller diameter mains. Therefore sufficient chlorine is required to ensure a residual at the extremities of the distribution system which can be. Experienced analysts can often determine the source of water from its taste, such as a borehole or River source.
Discoloured Water
Discoloured water in the distribution system could also be a problem, caused by internal corrosion of old iron mains. This deposit lies in the bottom of the main and only gives rise to complaints when it gets disturbed by changes in the flow volume, and comes out of peoples taps. These disturbances can be caused by, Increase or reversal of flow. Burst mains or valving operations. Use of fire hydrants by contractors
Remedy. The usual remedy is to flush the discoloured water out of the mains via hydrants.
Lead and Copper communication pipes can very occasionally be the source of complaint. The communication pipe running from the property boundary to the tap.Lead pipes can encourage mould growths and copper pipes carrying Shallow borehole water containing dissolved carbon dioxide can cause blue colouration in sinks.
Air
In Spring and Autumn with the changes in water and ground temperatures, air which is dissolved in the water and transparent becomes super saturated, as it warms up in the household pipes. On opening the tap the pressure is reduced and it appears as tiny bubbles so fine the water appears cloudy, or milky. This phenomenon is similar to opening a bottle of fizzy drink. Running the tap for a few seconds prevents this happening. Complaints are normally received concerning scum on cold drinks which is the air floating small pieces of fruit to the surface. Also from WHISKY drinkers.
Animals
Complaints of live organisms ( Zoo plankton) emerging from customers taps usually fall into a few categories. They are common in most supplies derived from surface water sources.
Asellus and Gammarus or Water Lice and freshwater shrimps , Snails , Chironomid or midge fly larvae , Aquatic Worms.
The Asellus or water louse is similar in appearance to the terrestrial wood louse. It grows to approximately 15 mm long and is flat. It does not swim but crawls along the interior of the water main, making it difficult to remove by flushing especially in old corroded mains. They breed twice a year in March and October , are resistant to normal chlorine levels and exist quite happily in the mains. The most effective way of removal is to dose with a small amount of pyrethrins which makes them loosen their grip then flushing though fire hydrants.
Gammarus or freshwater shrimps are free swimming and more easily removed by flushing alone. They grow to approx 10 mm and are often found associated with Asellus.
Snails
These are an infrequent problem in water mains but when found are difficult to remove completely.They cling to the interior of the main and are resistant to chlorine.They grow to about 5 mm and breed quite freely.
Chironomids See 22 Langford Quality Control

Worms
Complaints of worms are usually infrequent, and generally of Nais worms from the tap or earth worms in toilet pans.
Nais Worms
These are segmented bristle worms, which grow to approx 25 mm in length but are only about 1 mm thick. They proliferate in dead ends of mains where there is an accumulation of mains deposit. They are easily flushed out and are not widespread in occurrence.
Nematode Worms
These are very infrequently found and are smooth unsegmented and have no bristles. Flushing is an effective removal.
Earth Worms
These can be found in toilet pans, having crawled up the waste pipe, gaining entry from cracked drainage pipes or manhole covers.
Freshwater Mussels
Freshwater mussels are predominantly found in mains transporting untreated river water, if left they can readily colonise the mains reducing the flow. Periodic high doses of Chlorine usually solve the problem.


Microscopy is often used to identify smaller objects either low power or high power, according to the size of the object to be examined, with modern microscopes having cameras attached for record keeping.

The Williams “Wonder” Microscope circa 1912 priced at £2 7s 6d

Female Human Flea

Human Male Flea

Carnivorous Plant showing bladders to trap minute animacules